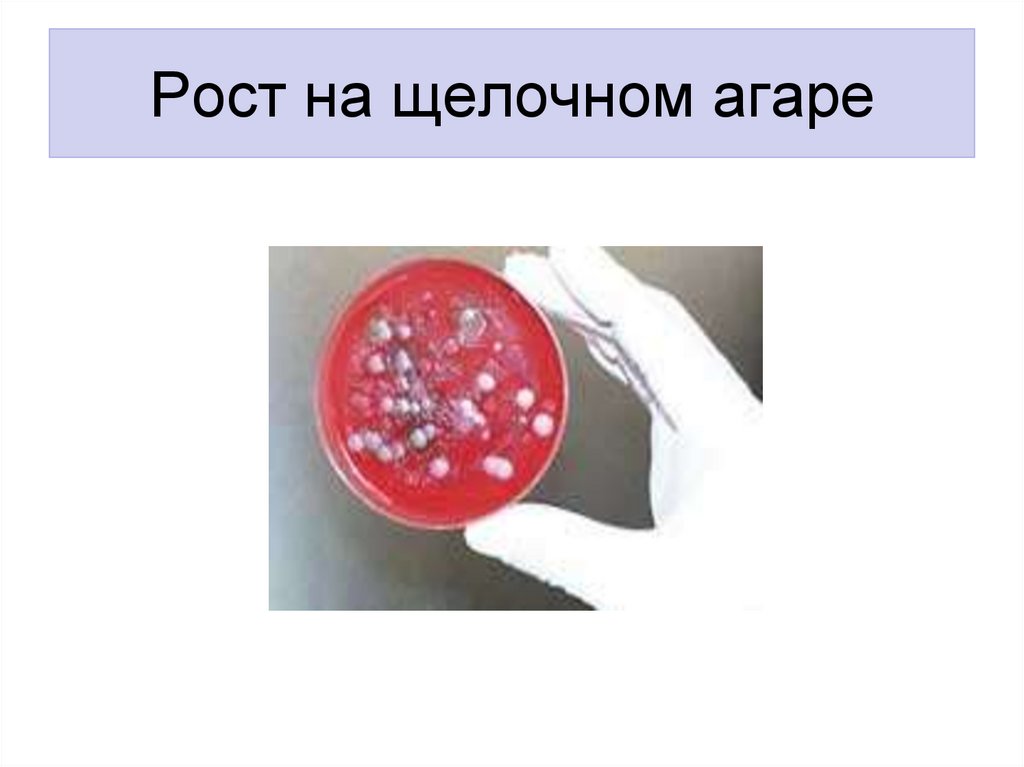
Рост на щелочном агаре

Similar presentations:
Микробиология холеры
1. Микробиология холеры
2. Холера
• Острое инфекционное заболевание,для
которого
типична
острая
обезвоживающая
диарея,
имеет
тенденцию
к
эпидемическому
распространению, тяжелое течение и
высокую летальность.
3. Историческая родина –Индия первая вспышка заболевания описана за 500 лет до н.э.
4.
V.cholerae –был открыт в
1883г.
Р.Кохом
биовар eltor –
в 1906г.
М.Готшлихом
5. Систематика
• Семейство - Vibrionaceae• Род - Vibrio
• Вид – V.cholerae
• Биовары: cholerae
proteus
eltor
albensis
___________
_________
истинные
холероподобные
6. МОРФОЛОГИЯ
7. V.cholerae. Electron microscopy.
8. Строгий аэроб, хемоорганотроф, мезофил. V.cholerae устойчивы к действию щелочи, убивающей большинство комменсалов ЖКТ, но
Культуральныесвойства
Строгий аэроб, хемоорганотроф,
мезофил.
V.cholerae устойчивы к действию щелочи,
убивающей большинство комменсалов
ЖКТ, но чувствительны к действию кислот.
Растет при температуре от 10 до 40 °С
(оптимальная 37 °С) на щелочных средах
(при рН до 9,2).
9. Рост на щелочном агаре
10. Антигенное строение
• Н –антиген – общий для всегорода Vibrio
• O-антиген –имеет 139
серовариантов, состоит из 3
субъединиц
11. Строение О-антигена
• А- присутствует во всех серовариантах• В
• С
АВС
Гикошима
АВ
Огава
АС
Инаба
12. Серотипы
13. НАГ-вибрионы
• 1992-1993 годы – в Китае, Индии,Малайзии началась крупная эпидемия
холеры.
• Возбудитель не агглютинировал ни с
одной сывороткой.
• Серовариант получил название -139
(НАГ).
• НАГ- на 90% гомологичен с другими
возбудителями
14. Факторы патогенности
• Высокая подвижность• Адгезины и факторы колонизации, связанные с фимбриями
• Муциназа (разрушает муцин и открывает доступ к
рецептору – ганглиозиду Gm1); нейраминидаза, протеазы,
гемагглютинин
• Эндотоксин, высвобождающийся при разрушении
вибрионов
• Главный фактор патогенности – холероген
термолабильный энтеротоксин.
-
15. Экзотоксин
Экзотоксин (холероген), М=84 кДаА
А1
А2
В
В1 В2 В3 В4 В5
16. Структура холерогена
17. Холероген
18. Холероген
В норме регуляция аденилатциклазы осуществляетсярегуляторным белком (Gs) и гуанозинтрифосфатом(GTP).
Однако, активация подавляется регуляторным белком(Gi) и
происходит гидролиз ГТФ.
19. Холероген
А1 субъединица холерного токсина прикрепляется к белку Gsс образованием комплекса (Gs-ADPR), и гидролиз ГТФ
становится невозможен. Поскольку гидролиз ГТФ является
ключевым событием для инактивации аденилатциклазы,
фермент остается в состоянии постоянной активации.
20.
21. Патогенез
• Источники• Пути передачи
• Входные ворота
• Важность инфицирующей дозы
22. Стадии патогенеза
• Инкубационный период (6ч-3 суток)• Холерный гастроэнтерит
• Холерный энтерит
• Холерный алгид
• Холерная кома
23. Патогенез холеры (продолжение)
Потеря воды и электролитов приводит к обезвоживаниюорганизма:
• Падает артериальное давление
• Нарушается микроциркуляция
• Развивается гипоксия тканей
• Метаболический ацидоз
• Гипокалиемия
• Острая почечная недостаточность
• Сердечная недостаточность
• Возможен гиповолемический шок
24.
25. Три типа течения заболевания по степени тяжести:
• 1. тяжелое течение – сопровождаетсятяжелой обезвоживающей диареей, может
приводить к смерти в течение суток
• 2. средней тяжести – сопровождается
выраженным обезвоживанием, но потеря
массы тела не превышает 3-5% за сутки
• 3. легкая степень – 1-3 % потеря веса за счет
обезвоживания
• 4.бактерионосительство (постинфекционное)
26. Специфическая профилактика и специфическая терапия
• Вакцина (смесь убитых вибрионовИнаба, Огава) – поствакцинальный
иммунитет не стойкий (8-12 месяцев)
• Анатоксин +О-АГ
• Серотерапия не разработана.

medicine
medicine








